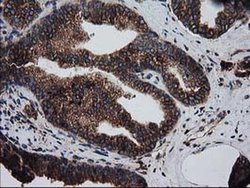
Invitrogen LMAN1 Monoclonal Antibody (OTI1E3) 100 &mu;L; Unconjugated:Antibodies,

missing translation for 'onlineSavingsMsg'
Learn More
Learn More
Invitrogen™ LMAN1 Monoclonal Antibody (OTI1E3)


Mouse Monoclonal Antibody
Brand: Invitrogen™ MA525346
This item is not returnable.
View return policy
Description
LMAN1 Monoclonal Antibody for Western Blot, ICC/IF, IHC (P), Flow
The protein encoded by this gene is a type I integral membrane protein localized in the intermediate region between the endoplasmic reticulum and the Golgi, presumably recycling between the two compartments. The protein is a mannose-specific lectin and is a member of a novel family of plant lectin homologs in the secretory pathway of animal cells. Mutations in the gene are associated with a coagulation defect. Using positional cloning, the gene was identified as the disease gene leading to combined factor V-factor VIII deficiency, a rare, autosomal recessive disorder in which both coagulation factors V and VIII are diminished.
Specifications
| LMAN1 | |
| Monoclonal | |
| 0.24 mg/mL | |
| PBS with 1% BSA, 50% glycerol and 0.02% sodium azide; pH 7.3 | |
| P49257 | |
| LMAN1 | |
| Full length human recombinant protein of LMAN1 produced in HEK293T cell. | |
| 100 μL | |
| Primary | |
| Human, Canine | |
| Antibody | |
| IgG1 |
| Flow Cytometry, Immunohistochemistry (Paraffin), Western Blot, Immunocytochemistry | |
| OTI1E3 | |
| Unconjugated | |
| LMAN1 | |
| 2610020P13Rik; AI326273; AU043785; C730041J05; EGK_09725; endoplasmic reticulum-golgi intermediate compartment protein 53; ERGIC53; ERGIC-53; ER-Golgi intermediate compartment 53 kDa protein; F5F8D; FMFD1; Gp58; intracellular mannose-specific lectin MR60; Lectin mannose-binding 1; lectin, mannose binding 1; lectin, mannose-binding, 1; LMAN1; MCFD1; MR60; P58; Protein ERGIC-53 | |
| Mouse | |
| Affinity chromatography | |
| RUO | |
| 3998, 476186 | |
| -20°C, Avoid Freeze/Thaw Cycles | |
| Liquid |
Product Content Correction
Your input is important to us. Please complete this form to provide feedback related to the content on this product.
Product Title
Spot an opportunity for improvement?Share a Content Correction